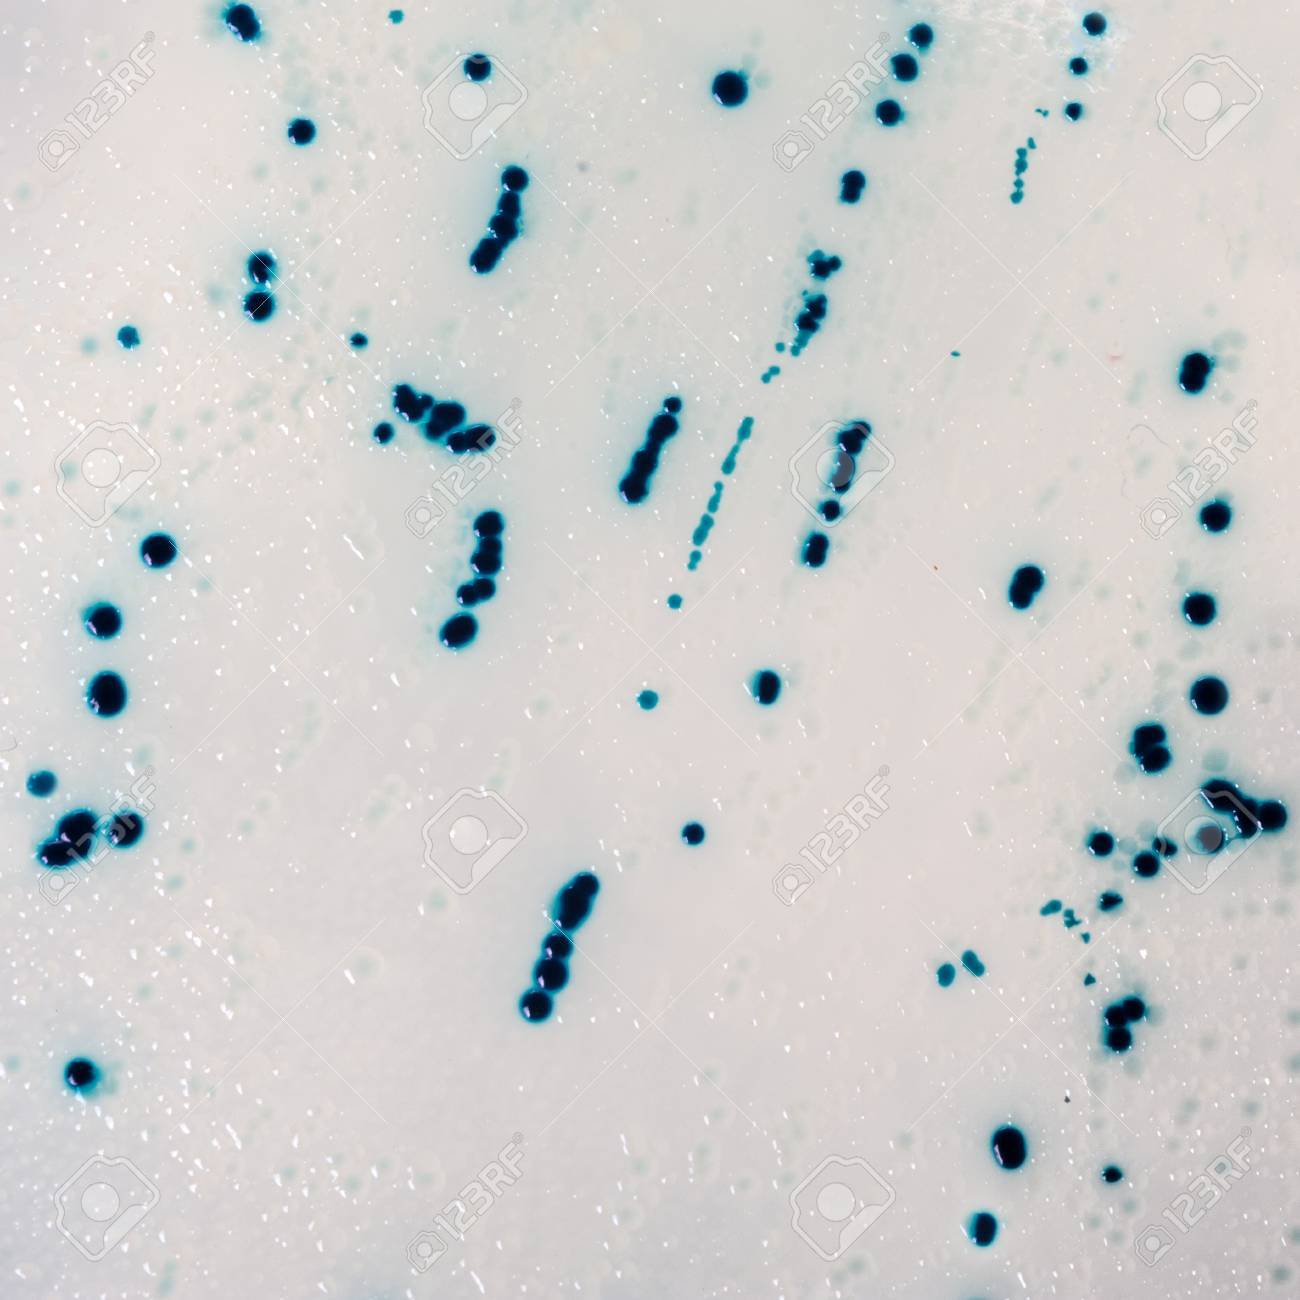
etiam-dictum-ipsum-a-felis

Download
Close
Автор:
id:
Ключевые слова:
agar, agar agar, amplification, background, bacteria, bacterial, bacterial colonies, bacterium, biotech, blue, blue white selection, cloning, colonies, control, dish, disposable, e coli, experiment, genetic modification, genetically modified organism, genetics, isolated, microbe, microbiology, modification, molecular biology, mutagenesis, mutation, natural, nature, petri dish, pharma, plastic, protection, research, sample, science, selection, square, yellow,





